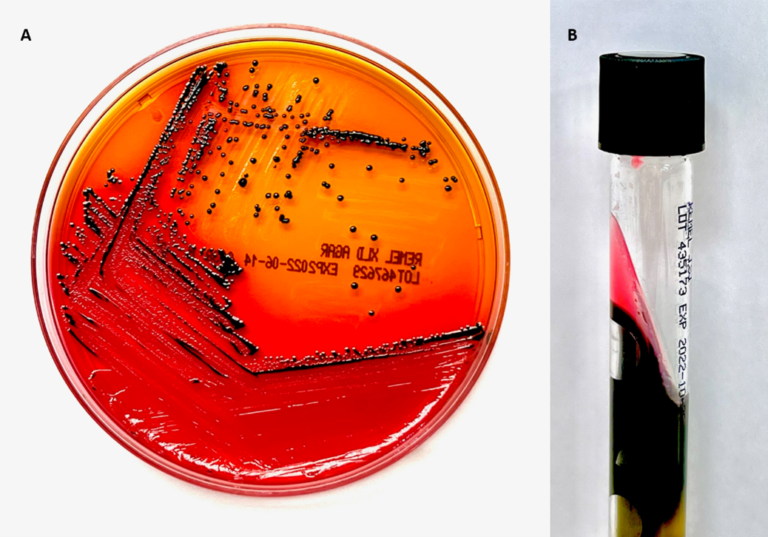

Infecciones gastrointestinales

Infecciones gastrointestinales
Las infecciones gastrointestinales son un padecimiento frecuente que genera en todo el mundo. La diarrea se define como 3 o más deposiciones en 24 horas. Se considera aguda si dura menos de 7 días, prolongada si dura de 7 a 13 días, persistente de 14 a 29 y crónica si son más de 30 días. Los agentes etiológicos pueden ser bacterias, virus y parásitos.
Microbioma gastrointestinal
El aparato gastrointestinal contiene una vasta y diversa microbiota normal. Normalmente, el intestino delgado superior contiene escasa microbiota (101 – 103/mL, de bacterias como Streptococcus, Lactobacillus y algunas levaduras). Pero, en el íleon distal, los conteos se encuentran entre 106 a 107/mL de bacterias como Enterobacterales y Bacteroides predominantemente.
El microbioma en este sitio asiste en el mantenimiento de la salud del ambiente y la fisiología del huésped, ya que provee vitaminas y nutrientes esenciales, influye en la respuesta inmune innata y adaptativa protegiendo la superficie de la mucosa. La microbiota varia entre personas, de acuerdo con la genética del huésped, estatus nutricional, consumo de antibióticos, antifúngicos o quimioterapia, y región geográfica. Los infantes son usualmente colonizados por la microbiota epitelial normal humana, como los Staphylococcus, Corynebacterium, etc., esto ocurre unas pocas horas después del nacimiento. Después, el contenido de la microbiota cambia. En un adulto el intestino grueso se coloniza relativamente temprano en la vida y contiene especies anaerobias como Bacteroides, Clostridium, Peptostreptococcus, Bifidobacterium y Eubacterium.

Diagnóstico, manejo y prevención por patógeno
Campylobacter: es una bacteria Gram negativa, en forma de espiral o bacilo curvo. La especie de C. jejuni es la que genera más infecciones en humanos y se trasmite por consumo de aves poco cocidas y leche no pasteurizada. Los síntomas se presentan de 1 a 3 días después de la exposición y duran una semana. La mayoría de los casos son autolimitados con fiebre, dolor abdominal, y diarrea (con sangre en un tercio de los casos). El método de referencia para el diagnóstico es el cultivo de heces. El tratamiento es de apoyo, en caso de que los síntomas sean severos se puede recetar azitromicina.

Salmonella: es un bacilo Gram negativo, móvil, anaerobio facultativo. Las especies no tifoidea son la causa más común de diarrea del viajero y gastroenteritis en Estados Unidos. La exposición comúnmente se relaciona a comida (huevos, lácteos no pasteurizados, aves poco cocidas) o animales (tortugas, iguanas, aves de corral). Los síntomas son comúnmente autolimitados. Los cultivos son especialmente considerados cuando los síntomas son severos o existe riesgo a trasmisión (manipuladores de comida o trabajadores de la salud). Los hemocultivos se realizan en pacientes con sepsis, inmunocomprometidos, hospitalizados o con válvulas cardiacas prostéticas. Los antibióticos se deben reservar para aquellos con mayor riesgo de complicaciones, porque es posible que no se reduzca la duración de la diarrea ni la fiebre y se corre el riesgo de aumentar la transmisión fecal.
Shigella: es un bacilo Gram negativo, anaerobio facultativo, no móvil, cercanamente relacionado con E. coli y es uno de los principales causantes de diarrea alrededor del mundo. Este patógeno y E. coli enteroinvasiva son los principales agentes causales de disentería bacilar, que se caracteriza por diarrea sanguinolenta. Los síntomas mediados por toxinas ocurren de 1 a 2 días después de la exposición e incluye diarrea, fiebre, dolor abdominal y tenesmo, duran alrededor de 5 a 7 días. El diagnóstico puede ser realizado por coprocultivo o PCR (reacción en cadena de la polimerasa). Los antibióticos reducen la duración de la disentería en pacientes con enfermedad moderadamente grave, pero no hay suficiente evidencia para recomendar una clase especifica de antibióticos.
Escherichia coli: tiene 6 patotipos que causan síntomas gastrointestinales, siendo la E. coli productora de toxina Shiga (STEC) el subtipo más común en brotes trasmitidos por los alimentos. Específicamente, E. coli O157:H7 se encuentra en el 36% de infecciones por STEC y los síntomas son más severos en comparación con otras. Los síntomas empiezan 3 a 4 días después de la exposición y pueden causar diarrea, dolor abdominal, y fiebre, duran alrededor de 6 a 7 días. La trasmisión es típicamente por leche no pasteurizada, sidra de manzana sin pasteurizar, quesos, agua contaminada y contacto con ganado. Los antibióticos no son recomendados y pueden incrementar el riesgo de síndrome urémico hemolítico.

Yersinia enterocolitica: es un bacilo anaerobio facultativo, Gram negativo que es más frecuente en el invierno. Se trasmite por comer carne de cerdo cruda o poco cocida, leche sin pasteurizar, agua sin tratar o contacto directo con animales. El periodo de incubación es de 4 a 6 días y el diagnóstico puede ser realizado por cultivo de heces, sangre, bilis, heridas, ganglios linfáticos mesentéricos, líquido cefalorraquídeo o peritoneal. La terapia antimicrobiana se puede considerar para los casos graves, pero no tienen efecto sobre las complicaciones postinfecciosas.

Listeria monocytogenes: es común en adultos mayores, con inmunocompromiso y mujeres embarazadas. Es un bacilo Gram positivo, anaerobio, móvil. Se trasmite por comida contaminada y transmisión mamá-feto. La listeriosis puede causar bacteriemia, meningitis, aborto espontaneo y muerte. En mujeres, la Listeria genera fiebre, síntomas gripales, dolor abdominal, vomito/diarrea, mialgia y dolor de garganta, estos síntomas se les debe poner mucha atención para realizar un diagnóstico. La listeriosis invasiva también es común en adultos mayores a 65 años. El diagnóstico puede ser realizado por cultivos de sangre o líquido cefalorraquídeo. El tratamiento antibiótico empírico puede ser considerado en mujeres embarazadas durante brotes o en aquellas con síntomas y fiebre. En personas inmunocomprometidas y embarazadas se debe recomendar que no consuman alimentos asociados con la presencia de Listeria.
Norovirus: es altamente contagioso y es una causa frecuente de gastroenteritis alrededor del mundo. Este virus genera brotes en hospitales, escuelas, guarderías, restaurantes, cruceros y buques. El periodo de incubación es entre 24 a 48 horas y el tratamiento se basa en corregir la deshidratación y anomalías de los electrolitos. El diagnóstico se realiza por PCR o inmunoensayos que son menos sensibles. La identificación temprana, notificación e implementación de medidas de control de infecciones como precauciones de contacto, lavado de manos con agua y jabón, desinfección con soluciones con cloro, uso de cubrebocas y cuarentena ayudan a reducir la trasmisión.

Rotavirus: es la causa más común de diarrea severa en infantes y niños menos de 5 años. La enfermedad ocurre alrededor del primer año de vida durante el invierto o primavera. Este virus tiene un periodo de incubación de 48 horas, causa vómitos, fiebre y diarrea acuosa con una duración de 3 a 8 días. Los métodos de diagnóstico más comunes son ELISA o métodos más sensibles como la PCR. Alternativamente, se puede usar microscopia electrónica o detección de anticuerpos por serología.

Crystosporidium: fue un patógeno muy común durante la epidemia del síndrome de inmunodeficiencia adquirida y se trasmite por exposición a agua, animales o contacto persona-persona. Un pequeño inoculo con 10 a 100 ooquistes pueden generar infección y estas estructuras sobreviven durante meses en agua o aceites y son resistentes a los químicos para purificar agua. Este patógeno causa infección autolimitada provocando diarrea acuosa, nausea, vomito y dolor abdominal. El diagnóstico se realiza por la detección del parasito por microscopía con tinciones especiales o detección de antígenos en heces, PCR o inmunoensayos. La nitazoxanida acorta la duración de la diarrea y excreción de parásitos en inmunocompetentes.

Giardia intestinalis: es el agente más común que causa infecciones parasitarias en humanos. Se trasmite por agua, comida o persona a persona. Las infecciones se presentan principalmente en el verano. La infección humana ocurre con la ingestión de alrededor de 10 quistes, y puede generar padecimientos crónicos y agudos. Los síntomas comunes incluyen diarrea, nausea, vomito, esteatorrea, dolor abdominal y pérdida de peso. El tratamiento inicial incluye metronidazol tinidazol o nitazoxanida.

Entamoeba histolytica: este parasito causa la disentería amebiana, y el medio de trasmisión es fecal-oral. Los factores de riesgo incluyen hacinamiento, sexo oral y anal, inmunosupresión y viaje a áreas endémicas. Este parasito puede causar diarrea y disentería fulminante. La enfermedad severa puede ser fatal o causar ulceras en colon, megacolon toxico, perforación o absceso hepático. Los métodos de diagnóstico incluyen test de anticuerpos, microscopía de las heces, ELISA y PCR. El tratamiento en infecciones sintomáticas es generalmente metronidazol seguido de paromomicina.

Bibliografía consultada
Sell, J., & Dolan, B. (2018). Common Gastrointestinal Infections. Primary Care: Clinics in Office Practice, 45(3), 519–532. doi:10.1016/j.pop.2018.05.008


Deja una respuesta